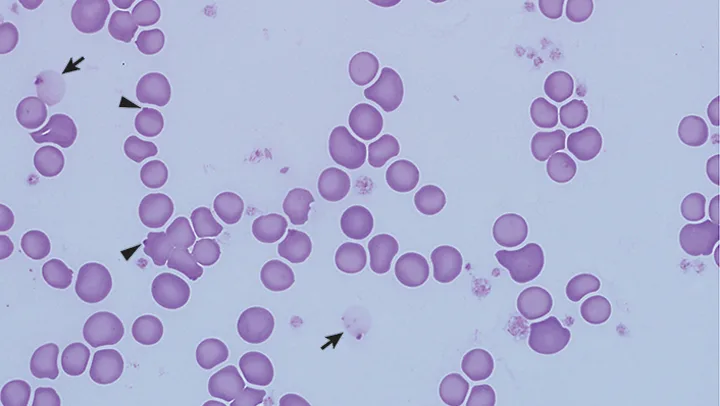
Featured Image

RBC Morphology Interpretation & Blood Film Review
Lisa M. Pohlman, DVM, MS, DACVP, Kansas State University
In the Literature
Newman AW, Rishniw M, Behling-Kelly E. Reporting and interpreting red blood cell morphology: is there discordance between clinical pathologists and clinicians? Vet Clin Pathol. 2014;43(4):487-495.
The Research …
To assist in ranking differential diagnoses, clinical pathologists (CPs) report RBC morphologies on CBC reports. However, reporting lacks consistency because there are no standards. Clinician interpretation of reports may vary.
Blood film from a dog. Eccentrocytes (arrows) result from oxidative damage to the erythrocyte membrane; membrane fusion occurs and hemoglobin is pushed to 1 side of the cell. Eccentrocytes may be seen with other indicators of oxidative damage (eg, Heinz bodies [arrowhead]). Modified Wright’s stain, 1000×

Blood film from a dog. This dog has a Heinz body (arrowheads) hemolytic anemia caused by eating fried onions. Ghost cells (arrows) are erythrocyte membranes that have lost their hemoglobin via hemolysis; their presence indicates that hemolysis occurred before blood film preparation (either intravascular or in vitro). The ghost cells shown here also contain red-staining Heinz bodies. Modified Wright’s stain,1000×
This study, via online surveys, examined the perceptions of CPs and clinicians with regard to the perceived value of reporting RBC morphologic abnormalities. Results from 1162 analyzable responses showed that some morphologies (eg, agglutination, spherocytes, polychromasia, Heinz bodies) were considered very useful to both clinicians and CPs. For other morphologies (eg, ghost cells, eccentrocytes), there was significant discordance between the groups: Most CPs deemed awareness of ghost cells or eccentrocytes very useful, whereas most clinicians disagreed. Of note, many clinicians admitted to being unfamiliar with the terms.
The study also addressed blood film review; 28% of clinicians indicated a perception that a CP reviews every blood film, whereas 19% of CPs reported that a CP reviews a blood film for every CBC submitted. Most CPs indicated that review of all blood films is impractical and that protocol dictates a technologist review blood films and refer smears for review only if certain criteria are met.
Explicating these discrepancies in clinical relevance, diagnostic expectations, and protocol standards will be an essential step toward better communication and improved patient care.
… The Takeaways
Key pearls to put into practice:
1. Ask the reference laboratory:
What are the criteria for blood film review?
How can I know if the blood smear was reviewed by a CP?
Is there a fee for a CP to review CBC submissions?
2. Call the laboratory, if necessary, to discuss the significance of the reported findings.
3. To receive complete information, provide a history and, ideally, the reason for submission.
CBC = complete blood count,_ CP = clinical pathologist, _RBC = red blood cell